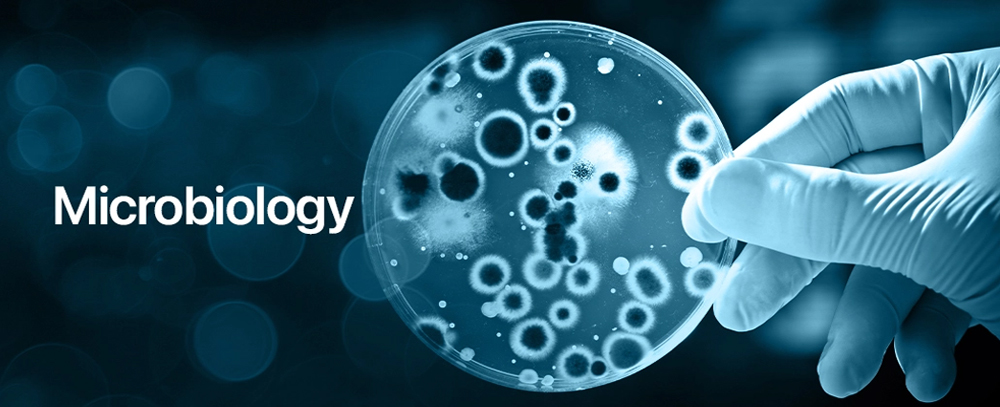

Department Of Anatomy

| Sr No. | Name | Qualification | Designation | Photo | |
|---|---|---|---|---|---|
| 1 | Dr. Prasad Kulkarni |
MS Anatomy | Professor |  |
|

Dr. Prasad Kulkarni
AEBAS Attend. ID : 95249703
Designation : Professor
Teaching Experience : 26 years
Medical Registration No.: MMC-75404
Professional Qualification(s): MS Anatomy
Nature of Employment (Regular / Contractual): Regular
|
|||||
| 2 | Dr. Zeba Khan |
MD Anatomy | Associate Professor |  |
|

Dr. Zeba Khan
AEBAS Attend. ID : 52157189
Designation : Associate Professor
Teaching Experience : 17 Years
Medical Registration No.: MCI-22213
Professional Qualification(s): MS Anatomy
Nature of Employment (Regular / Contractual): Regular
|
|||||
| 3 | Dr. Sachin Yadav |
MD Anatomy | Assistant Professor |  |
|

Dr. Sachin Yadav
AEBAS Attend. ID : 12423987
Designation : Assistant Professor
Teaching Experience : 11 Years
Medical Registration No.: MMC-2008041566
Professional Qualification(s): MS Anatomy
Nature of Employment (Regular / Contractual): Regular
|
|||||
Department Of Physiology

| Sr No. | Name | Qualification | Designation | Photo | |
|---|---|---|---|---|---|
| 1 | Dr. Anuj Shriram Ingole
|
MBBS, MD Physiology | Associate Professor & Head |  |
|

Dr. Anuj Shriram Ingole
AEBAS Attend. ID : 8184 4209
Designation : Associate Professor & Head
Teaching Experience : 18 years
Medical Registration No.: 2000/02/1116
Professional Qualification(s): MBBS, MD Physiology
Nature of Employment (Regular / Contractual): Regular
|
|||||
| 2 | Dr. Surekha Dongar Pardeshi
|
MBBS, MD Physiology | Assistant Professor |  |
|

Dr. Surekha Dongar Pardeshi
AEBAS Attend. ID : 8760 4574
Designation : Assistant Professor
Teaching Experience : 12 years
Medical Registration No.: 2008/04/0881
Professional Qualification(s): MBBS, MD Physiology
Nature of Employment (Regular / Contractual): Regular
|
|||||
| 3 | Dr. Vaishali Bhimrao Bansode
|
MBBS, MD, DNB Physiology | Assistant Professor |  |
|

Dr. Vaishali Bhimrao Bansode
AEBAS Attend. ID : 4361 1971
Designation : Assistant Professor
Teaching Experience : 12 years
Medical Registration No.: 2010/04/1388
Professional Qualification(s): MBBS, MD, DNB Physiology
Nature of Employment (Regular / Contractual): Regular
|
|||||
Department Of Biochemistry

| Sr No. | Name | Qualification | Designation | Photo | |
|---|---|---|---|---|---|
| 1 | Dr. Santosh Varma
|
MBBS, MD | Dean, Professor |  |
|

Dr. Santosh Varma
AEBAS Attend. ID : 86788685
Designation : Dean, Professor
Teaching Experience : 28 years
Medical Registration No.: 69235
Professional Qualification(s): MBBS, MD
Nature of Employment (Regular / Contractual): Regular
|
|||||
| 2 | Dr. Pankaj Kamble
|
MBBS, MD | Assistant Professor |  |
|

Dr. Pankaj Kambale
AEBAS Attend. ID : 42781027
Designation : Assistant Professor
Teaching Experience : 13 years
Medical Registration No.: 2008/06/2622
Professional Qualification(s): MBBS, MD
Nature of Employment (Regular / Contractual): Regular
|
|||||
| 3 | Dr. Anuja Nikam
|
MBBS, MD | Assistant Professor |  |
|

Dr. Anuja Nikam
AEBAS Attend. ID : 68253174
Designation : Assistant Professor
Teaching Experience : 5 years 5 months
Medical Registration No.: 2010/04/1388
Professional Qualification(s): MBBS, MD
Nature of Employment (Regular / Contractual): Regular
|
|||||
| 4 | Dr. Pooja Baviskar
|
MBBS, MD | Assistant Professor |  |
|

Dr. Pooja Baviskar
AEBAS Attend. ID : 53181718
Designation : Assistant Professor
Teaching Experience : 9 years
Medical Registration No.: 2016/06/1054
Professional Qualification(s): MBBS, MD
Nature of Employment (Regular / Contractual): Regular
|
|||||
Department Of Medicine

| Sr No. | Name | Designation | Qualification | Photo | |
|---|---|---|---|---|---|
| 1 | Dr. Amitkumar Potulwar
|
Assistant Professor | MBBS MD |  |
|

Dr Amitkumar Potulwar
AEBAS Attend. ID : 24078342
Designation : Assistant Professor
Teaching Experience : 4 years 5 month
Medical Registration No.: 2012/10/3108
Professional Qualification(s): MBBS MD
Nature of Employment (Regular / Contractual): Regular
|
|||||
| 2 | Dr. Aruna Shivsharan
|
Assistant Professor | MBBS MD |  |
|

Dr Aruna Shivasharan
AEBAS Attend. ID : 57867567
Designation : Assistant Professor
Teaching Experience : 2 years
Medical Registration No.: 79145
Professional Qualification(s): MBBS MD
Nature of Employment (Regular / Contractual): Contractual
|
|||||
| 3 | Dr. Atul Chauhan
|
Senior Resident | MBBS MD |  |
|

Dr Atul Chauhan
AEBAS Attend. ID : 99715642
Designation : Senior Resident
Teaching Experience : 11 years
Medical Registration No.: 2021/04/4066
Professional Qualification(s): MBBS MD
Nature of Employment (Regular / Contractual): Contractual
|
|||||
| 4 | Dr. Sonali Chavan
|
Senior Resident | MBBS MD |  |
|

Dr Sonali Chavan
AEBAS Attend. ID : 32163693
Designation : Senior Resident
Teaching Experience : 11 years
Medical Registration No.: 2021/05/4764
Professional Qualification(s): MBBS MD
Nature of Employment (Regular / Contractual): Contractual
|
|||||
| 5 | Dr. Yatin Vishe
|
Senior Resident | MBBS MD |  |
|

Dr Yatin Vishe
AEBAS Attend. ID : 21040605
Designation : Senior Resident
Teaching Experience : 5 years
Medical Registration No.: 2020/05/3339
Professional Qualification(s): MBBS MD
Nature of Employment (Regular / Contractual): Contractual
|
|||||
Department Of Pathology

| Sr No. | Name | Designation | Qualification | Photo | |
|---|---|---|---|---|---|
| 1 | Dr. Shivaji Birare
|
Professor & HOD | MD Pathology |  |
|

Dr. Shivaji Birare
AEBAS Attend. ID : 40791963
Designation : Professor & HOD
Teaching Experience : 28 Years, 10 months
Medical Registration No.: 70722
Professional Qualification(s): MD Pathology
Nature of Employment (Regular / Contractual): Regular
|
|||||
| 2 | Dr. Manish Gaikwad
|
Associate Professor | MD Pathology |  |
|

Dr. Manish Gaikwad
AEBAS Attend. ID : 48187748
Designation : Associate Professor
Teaching Experience : 10 Years, 6 months
Medical Registration No.: 2009020199
Professional Qualification(s): MD Pathology
Nature of Employment (Regular / Contractual): Regular
|
|||||
| 3 | Dr. Anupama Varma
|
Associate Professor | MD Pathology |  |
|

Dr. Anupama Varma
AEBAS Attend. ID : 25884917
Designation : Associate Professor
Teaching Experience : 7 Years, 5 months
Medical Registration No.: 73244
Professional Qualification(s): MD Pathology
Nature of Employment (Regular / Contractual): Contractual
|
|||||
| 4 | Dr. Gulshan Khatoon Ansari
|
Assistant Professor | MD Pathology |  |
|

Dr. Gulshan Khatoon Ansari
AEBAS Attend. ID : 87707568
Designation : Assistant Professor
Teaching Experience : 1 Year, 4 months
Medical Registration No.: 73244
Professional Qualification(s): MD Pathology
Nature of Employment (Regular / Contractual): Regular
|
|||||
| 5 | Dr. Hemangi Ingle
|
Assistant Professor | MD Pathology |  |
|

Dr. Hemangi Ingale
AEBAS Attend. ID : 05189131
Designation : Assistant Professor
Teaching Experience : 1 Year, 6 months
Medical Registration No.: 2013051967
Professional Qualification(s): MD Pathology
Nature of Employment (Regular / Contractual): Contractual
|
|||||
Department of Paediatrics

| Sr No. | Name | Qualification | Designation | Photo | |
|---|---|---|---|---|---|
| 1 | Dr. Naresh Dattatraya Sonkawade
|
MBBS, MD (Pediatrics), DNB (Pediatrics) FPCC |
Associate Professor |  |
|

Dr. Naresh Dattatraya Sonkawade
AEBAS Attend. ID : 96287083
Designation : Associate Professor
Teaching Experience : 8 years 5 months
Medical Registration No.: 2012/10/3065
Professional Qualification(s): MBBS, MD(Pediatrics), DNB (Pediatrics)
Nature of Employment (Regular / Contractual): Regular
|
|||||
| 2 | Dr. Tejasi Laxman Sawant
|
MBBS, MD (Pediatrics), DNB (Pediatrics) |
Assistant Professor |  |
|

Dr. Tejasi Laxman Sawant
AEBAS Attend. ID : 26147413
Designation : Assistant Professor
Teaching Experience : - years
Medical Registration No.: 2015/05/3022
Professional Qualification(s): MBBS, MD(Pediatrics), DNB (Pediatrics)
Nature of Employment (Regular / Contractual): Contractual
|
|||||
Department of Skin & VD (Dermatology and Venereology)

| Sr No. | Name | Designation | Qualification | Photo | |
|---|---|---|---|---|---|
| 1 | Dr.Shubham Suraj Gadkar
|
Assistant Professor | MBBS, MD, DNB (DVL) |  |
|

Dr. Shubham Suraj Gadkar
AEBAS Attend. ID : 10361432
Designation : Assistant Professor
Teaching Experience : 1 years
Medical Registration No.: 2020053200
Professional Qualification(s): MBBS, MD, DNB (DVL)
Nature of Employment (Regular / Contractual): Contractual
|
|||||
| 2 | Dr.Akshata Anil Mane
|
Senior Resident | MBBS, MD, DNB (DVL) |  |
|

Dr. Akshata Anil Mane
AEBAS Attend. ID : 85513424
Designation : Senior Resident
Teaching Experience : -
Medical Registration No.: 2021055334
Professional Qualification(s): MBBS, MD, DNB (DVL)
Nature of Employment (Regular / Contractual): Contractual
|
|||||
Department of Psychiatry

| Sr No. | Name | Designation | Qualification | Photo | |
|---|---|---|---|---|---|
| 1 | Dr Varsha Dawani
|
Associate Professor | MBBS, DPM, DNB (Psychiatry) |  |
|

Dr Varsha Dawani
AEBAS Attend. ID : 95753128
Designation : Associate Professor
Teaching Experience : 18 years
Medical Registration No.: 80590
Professional Qualification(s): MBBS, DPM, DNB (Psychiatry)
Nature of Employment (Regular / Contractual): Contractual
|
|||||
| 1 | Dr Ravindra Chavhan
|
Assistant Professor | MBBS,MD, DNB (Psychiatry) |  |
|

Dr Ravindra Chavhan
AEBAS Attend. ID : 07623246
Designation : Assistant Professor
Teaching Experience : 1.5 years
Medical Registration No.: 2004020572
Professional Qualification(s): MBBS,MD, DNB (Psychiatry)
Nature of Employment (Regular / Contractual): Regular
|
|||||
Department of General Surgery

| Sr No. | Name | Designation | Qualification | Photo | |
|---|---|---|---|---|---|
| 1 | Dr Vinaya Ambore
|
Professor and Head | MBBS,MS General Surgery,DNB General Surgery |  |
|

Dr Vinaya Ambore
AEBAS Attend. ID : 72532635
Designation : Professor and Head
Teaching Experience : 25 years
Medical Registration No.: 76046
Professional Qualification(s): MBBS,MS General Surgery,DNB General Surgery
Nature of Employment (Regular / Contractual): Regular
|
|||||
| 2 | Dr Shrutika Gurav
|
Assistant Professor | MBBS,MS General Surgery,DNB General Surgery |  |
|

Dr Shrutika Gurav
AEBAS Attend. ID : 29174724
Designation : Assistant Professor
Teaching Experience : 3 years
Medical Registration No.: 2018052353
Professional Qualification(s): MBBS,MS General Surgery,DNB General Surgery
Nature of Employment (Regular / Contractual): Regular
|
|||||
| 3 | Dr Karan Gulab Balani
|
Senior Resident | MBBS, MS General Surgery, Mch plastic Surgery |  |
|

Dr Karan Gulab Balani
AEBAS Attend. ID : 69498598
Designation : Senior Resident
Teaching Experience : 1.5 years
Medical Registration No.: 72472
Professional Qualification(s):MBBS, MS General Surgery, Mch plastic Surgery
Nature of Employment (Regular / Contractual): Contractual
|
|||||
| 4 | Dr Chandrakant Shivsharan
|
Senior Resident | MBBS, MS General Surgery |  |
|

Dr Chandrakant Shivsharan
AEBAS Attend. ID : 29222080
Designation : Senior Resident
Teaching Experience : 11 months
Medical Registration No.: 80631
Professional Qualification(s): MBBS, MS General Surgery
Nature of Employment (Regular / Contractual): Contractual
|
|||||
| 5 | Dr Gunjan Dodvani
|
Senior Resident | MBBS, DNB General Surgery |  |
|

Dr Gunjan Dodvani
AEBAS Attend. ID : 13507132
Designation : Senior Resident
Teaching Experience : 10 months
Medical Registration No.: 2005093549
Professional Qualification(s): MBBS, DNB General Surgery
Nature of Employment (Regular / Contractual): Contractual
|
|||||
Department of Orthopaedics

| Sr No. | Name | Designation | Department |
|---|---|---|---|
| 1 | Dr. Shorabh Sinha | Senior Resident | Orthopedics |
Department of ENT

| Sr No. | Name | Designation | Qualification | Photo | |
|---|---|---|---|---|---|
| 1 | Dr. Vijay Pawar
|
Assistant Professor and HOD | MBBS MS ENT |  |
|

Dr Vijay Pawar
AEBAS Attend. ID : 70651202
Designation : Assistant Professor and HOD
Teaching Experience : 1)1.5 y SR ship.
2)Assistant professor at GMC Ambernath 6 months Medical Registration No.: 2015041823
Professional Qualification(s): MBBS , MS ENT
Nature of Employment (Regular / Contractual): Regular
|
|||||
| 3 | Dr. Sonal Jaiprakash Yadav
|
Senior Resident | MBBS , MS ENT |  |
|

Dr Sonal Jaiprakash Yadav
AEBAS Attend. ID : 67172344
Designation : Senior Resident
Teaching Experience : 1) 1y SR ship at GMC Nagpur.
2)5 month SR ship at GMC Ambernath Medical Registration No.: 2019064967
Professional Qualification(s): MBBS , MS ENT
Nature of Employment (Regular / Contractual): Contractual
|
|||||
Department of Ophthalmology

| Sr No. | Name | Designation | Qualification | Photo | |
|---|---|---|---|---|---|
| 1 | Dr Neha Kawali
|
Assisstant professor | MBBS,DNB OPHTHALMOLOGY |  |
|

Dr Neha Kawali
AEBAS Attend. ID : 69477251
Designation : Assisstant professor
Teaching Experience : 2 years
Medical Registration No.: MMC 2018105012
Professional Qualification(s): MBBS, DNB OPHTHALMOLOGY
Nature of Employment (Regular / Contractual): Contractual
|
|||||
| 2 | Dr Bisma Ansari
|
Senior Resident | MBBS,MS OPHTHALMOLOGY |  |
|

Dr Bisma Ansari
AEBAS Attend. ID : 88369284
Designation : Senior resident
Teaching Experience : -
Medical Registration No.: MMC 2020053777
Professional Qualification(s): MBBS, MS OPHTHALMOLOGY
Nature of Employment (Regular / Contractual): Regular
|
|||||
Department of Obstetrics and Gynaecology

| Sr No. | Name | Qualification | Designation | Photo | |
|---|---|---|---|---|---|
| 1 | Dr. Trupti Rokade
|
MS OBGY | Associate Profesor and Additional Civil Surgeon |
 |
|

Dr. Trupti Rokade
AEBAS Attend. ID : 79801757
Designation : Associate Profesor and
Additional Civil Surgeon Teaching Experience : 7 years
Medical Registration No.: 2005020629
Professional Qualification(s): MS OBGY
Nature of Employment (Regular / Contractual): Regular
|
|||||
| 2 | Dr. Ritu Balani
|
MD OBGY | Assistant Professor |  |
|
|
<

Dr. Ritu Balani
AEBAS Attend. ID : 34850479
Designation : Assistant Professor
Teaching Experience : 1 years
Medical Registration No.: MMC 65670
Professional Qualification(s): MD OBGY
Nature of Employment (Regular / Contractual): Contractual
|
|||||
Department of Anaesthesiology

| Sr No. | Name | Designation | Qualification | Photo | |
|---|---|---|---|---|---|
| 1 | Dr Vaishali Mohol
|
Professor | MBBS MD |  |
|

Dr Vaishali Mohol
AEBAS Attend. ID : 60283911
Designation : Professor
Teaching Experience : 28 years
Medical Registration No.: 81455
Professional Qualification(s): MBBS MD
Nature of Employment (Regular / Contractual): Regular
|
|||||
| 2 | Dr Nilesh Jawe
|
Associate Professor | MBBS MD |  |
|

Dr Nilesh Jawe
AEBAS Attend. ID : 80532373
Designation : Associate Professor
Teaching Experience : 10 years 6 months
Medical Registration No.: 2010/04/0836
Professional Qualification(s): MBBS MD
Nature of Employment (Regular / Contractual): Regular
|
|||||
| 3 | Dr Yogesh Suryawanshi
|
Associate Professor | MBBS MD |  |
|

Dr Yogesh Suryawanshi
AEBAS Attend. ID : 27757528
Designation : Associate Professor
Teaching Experience : 11 years
Medical Registration No.: 2010/04/0850
Professional Qualification(s): MBBS MD
Nature of Employment (Regular / Contractual): Regular
|
|||||
Department of Dentistry

| Sr No. | Name | Qualification | Designation | Photo | |
|---|---|---|---|---|---|
| 1 | Dr. Rajendra Avhad
|
MDS | Associate Professor |  |
|

Dr.Rajendra Avhad
AEBAS Attend. ID : 72182740
Designation : Associate Professor
Teaching Experience : 14 years
Medical Registration No.:A-13035
Professional Qualification(s): MDS
Nature of Employment (Regular / Contractual): Regular
|
|||||
| 2 | Dr.Kalpana Rakshit
|
MDS | Assistant Professor |  |
|

Dr.Kalpana Rakshit
AEBAS Attend. ID : 05724457
Designation : Assistant Professor
Teaching Experience : 2 years 05 month
Medical Registration No.: A-21445
Professional Qualification(s): MDS
Nature of Employment (Regular / Contractual): Contractual
|
|||||
| 2 | Dr.Pradnya Salian
|
MDS | Senior Resident |  |
|

Dr.Pradnya Salian.
AEBAS Attend. ID : 46954502
Designation : Senior Resident
Teaching Experience : 0 years
Medical Registration No.: A-47611
Professional Qualification(s): MDS
Nature of Employment (Regular / Contractual): Contractual
|
|||||
Department of Pharmacology

| Sr No. | Name | Designation | Qualification | Photo | |
|---|---|---|---|---|---|
| 1 | Dr.Sanjeevani Mukundrao Chawre
|
Associate Professor | MD.Pharma |  |
|

Dr.Sanjeevani Mukundrao Chawre
AEBAS Attend. ID : 79936220
Designation : Associate Professor
Teaching Experience : 10 years 4 Month
Medical Registration No.: 2008/09/343118/03/2015
Professional Qualification(s): MD.Pharma
Nature of Employment (Regular / Contractual): Regular
|
|||||
| 2 | Dr. Samiksha Sanjay Shelar
|
Assistant Professor | MD.Pharma |  |
|

Dr.Samiksha Sanjay Shelar
AEBAS Attend. ID : 01903336
Designation : Assistant Professor
Teaching Experience : 2 years 8 Month
Medical Registration No.: 2015/06/387425/10/2021
Professional Qualification(s): MD.Pharma
Nature of Employment (Regular / Contractual): Regular
|
|||||
| 3 | Dr. Alok Mulay
|
Senior Resident | MD.Pharma |  |
|

Dr.Alok Mulay
AEBAS Attend. ID : 63329199
Designation : Senior Resident
Teaching Experience : -
Medical Registration No.: 200903086104/07/2025
Professional Qualification(s): MD.Pharma
Nature of Employment (Regular / Contractual): Contractual
|
|||||
Department of Microbiology
| Sr No. | Name | Qualification | Designation | Photo | |
|---|---|---|---|---|---|
| 1 | Dr Santosh Mangalkar
|
MD Microbiology | Professor and HOD |  |
|

Dr Santosh Mangalkar
AEBAS Attend. ID : 69403873
Designation : Professor and HOD
Teaching Experience : 17 years
Medical Registration No.: 65615
Professional Qualification(s): MD MicrobiologyD Microbiology
Nature of Employment (Regular / Contractual): Regular
|
|||||
| 2 | Dr Poonam Sayare
|
MD Microbiology | Assistant Professor |  |
|

Dr Poonam Sayare
AEBAS Attend. ID : 79186706
Designation : Assistant Professor
Teaching Experience : 9 years
Medical Registration No.: 2025/11/11866
Professional Qualification(s): MD Microbiology
Nature of Employment (Regular / Contractual): Regular
|
|||||
| 3 | Dr Vasanti Visawale
|
MD Microbiology | Assistant Professor |  |
|

Dr Vasanti Visawale
AEBAS Attend. ID : 30961904
Designation : Assistant Professor
Teaching Experience : 2 years
Medical Registration No.: 2018/06/2868
Professional Qualification(s): MD Microbiology
Nature of Employment (Regular / Contractual): Contractual
|
|||||
| 4 | Dr Divya Shekokar
|
MD Microbiology | Assistant Professor |  |
|

Dr Vasanti Visawale
AEBAS Attend. ID : 30961904
Designation : Assistant Professor
Teaching Experience : 2 years
Medical Registration No.: 2018/06/2868
Professional Qualification(s): MD Microbiology
Nature of Employment (Regular / Contractual): Contractual
|
|||||
| 5 | Dr Foramben Patel
|
MD Microbiology | Senior Resident |  |
|

Dr Foramben Patel
AEBAS Attend. ID : 28102060
Designation : Senior Resident
Teaching Experience : 9 months
Medical Registration No.: 2019/05/3936
Professional Qualification(s): MD Microbiology
Nature of Employment (Regular / Contractual): Bonded
|
|||||
| 6 | Dr Jeswin George
|
MD Microbiology | Senior Resident |  |
|

Dr Jeswin George
AEBAS Attend. ID : 49215417
Designation : Senior Resident
Teaching Experience : 5 months
Medical Registration No.: 2016/03/0396
Professional Qualification(s): MD Microbiology
Nature of Employment (Regular / Contractual): Bonded
|
|||||
Department of Community Medicine

| Sr No. | Name | Qualification | Qualification | Photo | |
|---|---|---|---|---|---|
| 1 | Dr Sangita C.Shelake
|
MD Community Medicine | Professor |  |
|

Dr Sangita C.Shelake
AEBAS Attend. ID : 27515871
Designation : Professor
Teaching Experience : 30 Years
Medical Registration No.: 67867
Professional Qualification(s): MD Community Medicine
Nature of Employment (Regular / Contractual): Regular
|
|||||
| 2 | Dr Vaishali N.Bahattare
|
MD Community Medicine | Associate Professor |  |
|

Dr Vaishali N.Bahattare
AEBAS Attend. ID : 10478386
Designation : Associate Professor
Teaching Experience : 17 Years
Medical Registration No.: 2001072743
Professional Qualification(s): MD Community Medicine
Nature of Employment (Regular / Contractual): Regular
|
|||||
| 3 | Dr. Manisha Laxman Bendhari
|
MD Community Medicine | Associate Professor |  |
|

Dr. Manisha Laxman Bendhari
AEBAS Attend. ID : 64695238
Designation : Associate Professor
Teaching Experience : 9 Years
Medical Registration No.: 2009/04/1637
Professional Qualification(s): MD Community Medicine
Nature of Employment (Regular / Contractual): Contractual
|
|||||
| 4 | Dr. Mohini Gulabsingh Pawara
|
MD Community Medicine | Senior Resident |  |
|

Dr. Mohini Gulabsingh Pawara
AEBAS Attend. ID : 17016748
Designation : Senior Resident
Teaching Experience : 1 Years
Medical Registration No.: 2021/06/5951
Professional Qualification(s): MD Community Medicine
Nature of Employment (Regular / Contractual): Bonded Contractual
|
|||||
| 5 | Dr. Deepika Vinayak Morale
|
MD Community Medicine | Senior Resident |  |
|

Dr. Deepika Vinayak Morale
AEBAS Attend. ID : 93422890
Designation : Senior Resident
Teaching Experience : 1 Years
Medical Registration No.: 2018/04/1322
Professional Qualification(s): MD Community Medicine
Nature of Employment (Regular / Contractual): Bonded Contractual
|
|||||
| 6 | Dr. Jaiganesh R.
|
MD Community Medicine | Senior Resident |  |
|

Dr. Jaiganesh R.
AEBAS Attend. ID : 32113692
Designation : Senior Resident
Teaching Experience : 1 Years
Medical Registration No.: 2022/08/6491
Professional Qualification(s): MD Community Medicine
Nature of Employment (Regular / Contractual): Bonded Contractual
|
|||||
Department of Forensic and Toxicology Medicine

| Sr No. | Name | Qualification | Designation | Photo | |
|---|---|---|---|---|---|
| 1 | Dr. Ramesh Kashinath Gadhari
|
MBBS, MD (Forensic Medicine) | Professor and HOD |  |
|

Dr. Ramesh Kashinath Gadhari
AEBAS Attend. ID : 2190 5284
Designation : Professor and HOD
Teaching Experience : 12 years 1 month
Medical Registration No.: 2006/02/0630
Professional Qualification(s): MBBS, MD (Forensic Medicine)
Nature of Employment (Regular / Contractual): Regular
|
|||||
| 2 | Dr. Prashant Bhimrao Waghmare
|
MBBS, MD (Forensic Medicine), LLB,PhD (Sch) |
Associate Professor |  |
|

Dr. Prashant Bhimrao Waghmare
AEBAS Attend. ID : 1843 2707
Designation : Associate Professor
Teaching Experience : 09 years 1 month
Medical Registration No.: 2007/04/0676
Professional Qualification(s): MBBS, MD (Forensic Medicine), LLB, PhD (Sch)
Nature of Employment (Regular / Contractual): Regular
|
|||||
| 3 | Dr. Dattatray Vitthal Bhore
|
MBBS, MD (Forensic Medicine) | Assistant Professor |  |
|

Dr. Dattatray Vitthal Bhore
AEBAS Attend. ID : 3545 4543
Designation : Assistant Professor
Teaching Experience : 10 years 7 months
Medical Registration No.: 2011/06/2049
Professional Qualification(s): MBBS, MD (Forensic Medicine)
Nature of Employment (Regular / Contractual): Regular
|
|||||